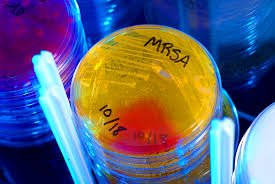

تم نقل جو جويا إلى أحد المستشفيات عشان يجرون لها عمليه جراحية طارئة
وهذا المستشفى جلس يتتبع اسباب حاله جو الصحيه وكيف تدهورت بسرعه كبيره ?
وهذا المستشفى جلس يتتبع اسباب حاله جو الصحيه وكيف تدهورت بسرعه كبيره ?
لاحقا انه تبين انه فعلا صديقه جو كانت مصابه بعدوى بكتيريا ستاف وكانت مصدر الإصابة ?
أثرت العدوى على عمودها الفقري بشكل كبير
وكانوا الأطباء فاقدين الأمل انه ترجع لها الحركة
وراح تستخدم الكرسي المتحرك لبقيه عمرها ??
وكانوا الأطباء فاقدين الأمل انه ترجع لها الحركة
وراح تستخدم الكرسي المتحرك لبقيه عمرها ??
بس مع اصرار جو و العلاج الطبيعي المكثف تستعيد الحركه في رجولها ببطئ.
هذا رابط الخبر
cbsnews.com
cbsnews.com
حالة جو وقصه انتقال العدوى لها تعتبر غريبه نوعا ما
ولكن ترا مهي بعيده عن الواقع
مشاركه الأشياء الشخصيه راح تتسبب بإنتقال العدوى بكل تأكيد بين الناس
ومستلزمات التجميل ليست مستثناه ??
ولكن ترا مهي بعيده عن الواقع
مشاركه الأشياء الشخصيه راح تتسبب بإنتقال العدوى بكل تأكيد بين الناس
ومستلزمات التجميل ليست مستثناه ??
طيب خلونا نتعرف بشكل اكبر على خطوره هذي البكتريا ?‼️
لأنها مقاومه للادويه والعلاج غالبا ماتسبب بكتريا MRSA مضاعفات خطيرة وعدوى واسعة النطاق.
وفي الحالات الشديدة ممكن تتسبب بإلتهابات للجلد ينتج عنه موت الانسجة (necrosis)
وفي الحالات الشديدة ممكن تتسبب بإلتهابات للجلد ينتج عنه موت الانسجة (necrosis)
مضاعفات بكتريا ال MRSA
?خراج في المخ او الحبل الشوكي (التهابات الجهاز العصبي)
?التهابات الانسجة الضامه
?التهاب الغشاء المحيط بالقلب
?فشل الأعضاء (مثلا الكلى)
?التهاب نخاع العظم
?التهاب الحلق
?التهاب الجهاز التنفسي
?التهاب المفاصل
?تسمم الدم
?متلازمه الصدمه السمية
?خراج في المخ او الحبل الشوكي (التهابات الجهاز العصبي)
?التهابات الانسجة الضامه
?التهاب الغشاء المحيط بالقلب
?فشل الأعضاء (مثلا الكلى)
?التهاب نخاع العظم
?التهاب الحلق
?التهاب الجهاز التنفسي
?التهاب المفاصل
?تسمم الدم
?متلازمه الصدمه السمية
جاري تحميل الاقتراحات...